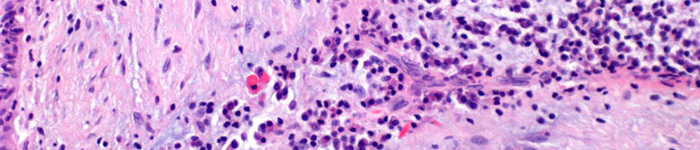

VI-1 Cistoadenoma papilar linfomatoso
Es un tumor benigno, que es generalmente conocido con la denominación eponémica de tumor de Warthin (Alfred Scott Warthin -1866-1931-, profesor de Patología de la Universidad de Michigan). Afecta fundamentalmente al lóbulo superficial de la glándula parótida representando aproximadamente el 5% de los tumores parotídeos: Es más frecuente en varones, en edad avanzada (5ª a 7ª década) y en un 10-15% de los cos casos se presenta con un carácter bilateral -sincrónico o metacrónico-. Su imagen histológica es muy característica estando constituida por espacios quísticos en cuyo interior aparecen proyecciones papilares revestidas por dos capas de células epiteliales cilíndricas eosinófilicas, con cambios citoplasmáticos oncocíticos. Obsérvese como en estas dos capas celulares, la capa interna presenta los núcleos polarizados hacia porción basal, mientras que la capa superficial los núcleos están polarizados hacia la porción apical. El estroma de las papilas presenta folículos linfoides con centros claros germinales que recuerdan la estructura propia de un ganglio linfático y de hecho estos tumores se considera que surgen como resultado de un crecimiento epitelial de restos ductales salivales atrapados en el interior de ganglios adyacentes a la glándula parótida. El caso que se presenta en esta práctica corresponde a una forma incipiente de crecimiento tumoral en el interior de una adenopatía muy cercana al tejido parotideo. El preparado es el mismo visto en la practica I-2 (Lipomatosis –infiltración grasa de parótida) y debe recordar como la lipomatosis parotídea, al igual que el tumor de Warthin, es una lesión frecuente en los sujetos de edad avanzada.



VI-2 Odontoma compuesto
El odontoma es un frecuente tumor benigno odontogénico, de carácter hamartomatoso, formador de esmalte maduro, dentina y pulpa, llegando el tumor a conformar pequeñas y múltiples (de 2 a 30) estructuras dentales en miniatura (dentículos). Es una forma de tumor odontogénico maduro que recapitula en su morfología las fases finales de la odontogénesis. Se presenta generalmente en la 1ª o 2º década de la vida, en ocasiones en relación a una estructura dental no erupcionada o con retardo en la erupción, la mayor parte de las veces afectando a la parte anterior del maxilar: Histológicamente se aprecia la estructura de estos dentículos que presentan una forma y tamaño irregular, generalmente con un contorno cónico, situados de forma cercana, presentando esmalte, dentina y un tejido pulpar, en un patrón histológico maduro y organizado, donde es posible reconocer odontoblastos funcionales. Cada dentículo a menudo esta rodeado de una fina banda de tejido conjuntivo folicular, que puede contener residuos odontógenos y focos de calcificación.